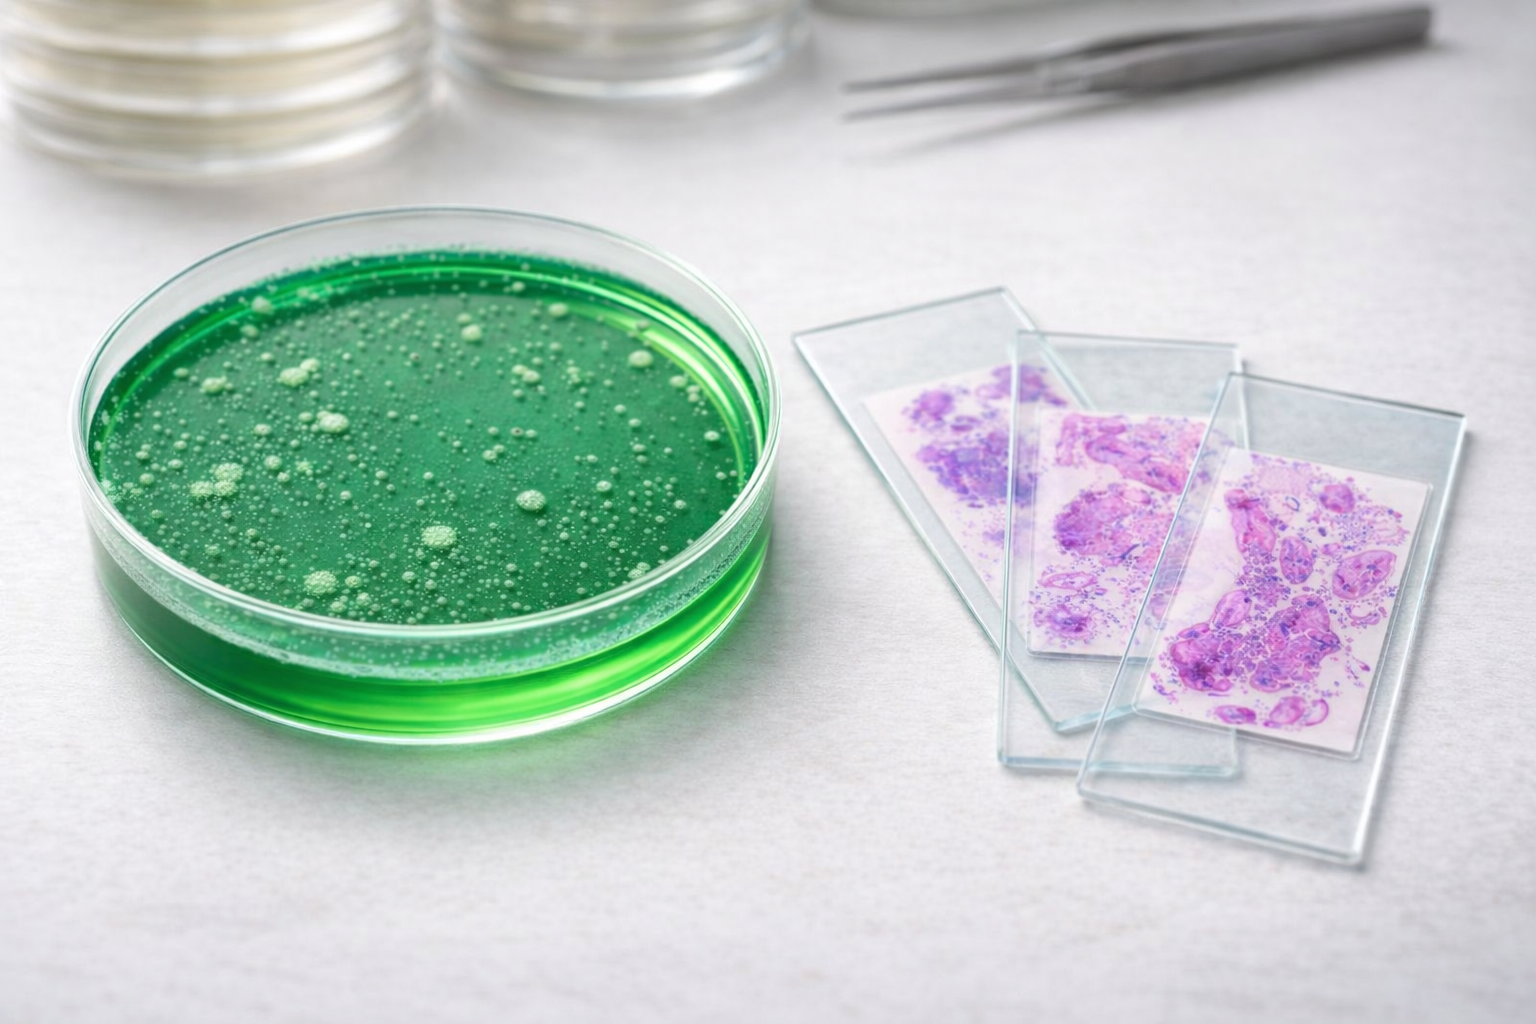
Image Description

Welcome to Chicago Board Review Series (CBRS)
Join us for Chicago Board Review Series: Intense yet breezy courses focusing on high-yield topics in Anatomic and Clinical Pathology. Upcoming couse event scheduled for April 25-26, 2026

About Our President and Course Director of the CBRS
Dr. Vijayalakshmi (Viju) Ananthanarayanan
President and Course Director
Chicago Board Review Series (CBRS)
Hello, My name is Dr. Vijayalakshmi (Viju) Ananthanarayanan. My journey into pathology started about 20 years ago. I completed my AP/CP training from University of Chicago and completed my fellowship in Surgical and Thoracic Pathology.
As a new faculty member at Loyola University, I was involved in clinical diagnostics of thoracic neoplastic and non-neoplastic disorders, transplant pathology and head and neck pathology.
Learn More
Frequently Asked Questions
When and where is the upcoming Chicago Board Review Series course event taking place?
The upcoming course event is scheduled for April 25-26, 2026 on Zoom
Are the Chicago Board Review Series courses suitable for all levels of expertise?
Yes, our courses are designed to cater to a wide range of expertise levels, from beginners to advanced learners, seeking a high-intensity rapid review
What topics are covered in the Chicago Board Review Series courses?
Our courses cover high-yield topics in both Anatomic and Clinical Pathology (AP and CP) to provide a comprehensive review for attendees
How can I register for the Chicago Board Review Series course event?
You can easily register for our courses by visiting our website and following the registration instructions provided for the upcoming event